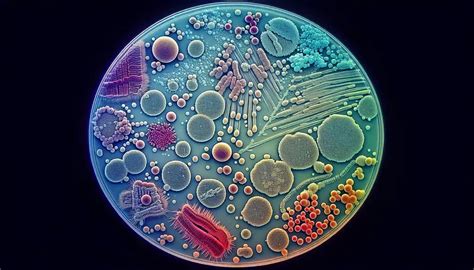
Microscopio mostrando colonias bacterianas en un material poroso

La calidad del agua en un acuario es un factor determinante para la salud y el bienestar de sus habitantes. Una parte fundamental de mantener esta calidad recae en el sistema de filtración, y dentro de él, los canutillos cerámicos juegan un rol de suma importancia, especialmente en lo que respecta a la filtración biológica. Este artículo explorará en profundidad qué son los canutillos cerámicos, su función esencial, y las diversas formas en que pueden ser utilizados, desmitificando algunas dudas comunes y ofreciendo una perspectiva clara sobre su aplicación óptima.
¿Qué son los Canutillos Cerámicos y Por Qué Son Tan Importantes?
Los canutillos cerámicos, también conocidos como material biológico o bio-bolas, son pequeños cilindros porosos fabricados a partir de materiales cerámicos. Su diseño, caracterizado por su alta porosidad tanto en la superficie exterior como en la interior, les confiere una enorme área disponible para que se alojen bacterias beneficiosas. Estas bacterias microscópicas son las verdaderas protagonistas de la filtración biológica, encargadas de transformar compuestos tóxicos, como el amoníaco y los nitritos, en sustancias menos perjudiciales para los peces.
La superficie de los canutillos cerámicos es significativamente mayor que la de otros materiales filtrantes convencionales. Esta vasta área de contacto es ideal para que las bacterias nitrificantes, como las Nitrosomonas y Nitrobacter, establezcan colonias robustas. Estas bacterias son esenciales para el ciclo del nitrógeno, un proceso natural pero vital en cualquier acuario cerrado. Sin una colonia bacteriana adecuada, el amoníaco excretado por los peces y proveniente de la descomposición de materia orgánica se acumularía rápidamente, alcanzando niveles tóxicos que podrían ser fatales para los habitantes del acuario.
La Función Primordial: Filtración Biológica
La principal función de los canutillos cerámicos es albergar y soportar la colonia bacteriana responsable de la filtración biológica. Cuando el agua del acuario circula a través del filtro y entra en contacto con los canutillos, las bacterias adheridas a su superficie actúan como un equipo de limpieza biológica.
El proceso se desarrolla en dos etapas principales:
- Amonificación: Las bacterias Nitrosomonas convierten el amoníaco (NH₃), altamente tóxico, en nitritos (NO₂⁻), que aunque menos tóxicos, siguen siendo perjudiciales.
- Nitrificación: Posteriormente, las bacterias Nitrobacter transforman los nitritos (NO₂⁻) en nitratos (NO₃⁻), que son considerablemente menos tóxicos y pueden ser absorbidos por las plantas como nutriente o eliminados mediante cambios de agua.

La eficacia de este proceso depende directamente de la cantidad de bacterias beneficiosas presentes y de la disponibilidad de amoníaco y nitritos para su consumo. Es aquí donde la ubicación y la circulación del agua juegan un papel crucial.
¿Deben los Canutillos Cerámicos Estar Obligatoriamente Dentro del Filtro?
La pregunta sobre si los canutillos cerámicos deben colocarse exclusivamente dentro de un filtro es recurrente entre los acuaristas. Si bien la respuesta más directa y eficiente es "sí", es importante comprender el porqué.
Cuando los canutillos se alojan dentro de un filtro, se benefician de una circulación de agua constante y a menudo a mayor velocidad. Este flujo continuo asegura un suministro constante de desechos orgánicos y nutrientes, que son el alimento para las bacterias. Cuantos más desechos lleguen al material filtrante, mayor será la población bacteriana que pueda desarrollarse y multiplicarse, lo que se traduce en una mayor capacidad para procesar nitritos y amoníaco, y por ende, una menor concentración de sustancias nocivas en el agua.
Si los canutillos se colocan directamente sobre el sustrato del acuario, la circulación del agua es significativamente menor y más errática. Aunque se formarán colonias de bacterias, estas no recibirán el mismo "banquete" de nutrientes que obtendrían en un filtro. La disponibilidad de desechos será limitada, impidiendo que se aproveche al máximo la gran capacidad del material filtrante. En este escenario, solo se alojarán algunas bacterias, se alimentarán pobremente y su multiplicación será mínima, manteniendo una población bacteriana reducida.

Implicaciones de Colocar Canutillos Fuera del Filtro
Intentar replicar la función de un filtro colocando canutillos fuera de él, por ejemplo, como parte del sustrato junto a las piedrecillas de grava, presenta varias desventajas:
- Circulación de Agua Limitada: Como se mencionó, la baja circulación de agua impide un suministro adecuado de nutrientes para las bacterias, limitando su crecimiento y eficacia.
- Menor Eficiencia de Filtración: La capacidad de retención de impurezas y la transformación de compuestos tóxicos se ven drásticamente reducidas.
- Posible Acumulación de Amoníaco: En el peor de los casos, si las bacterias no son capaces de consumir todo el amoníaco generado, este se acumulará en el agua, creando un ambiente tóxico para los peces. Incluso si se logra un equilibrio, este podría ser muy frágil y colapsar fácilmente ante cualquier alteración, como una sobrealimentación o la adición de materia orgánica.
- Impacto Estético: Colocar material filtrante visible en el sustrato o entre las decoraciones puede afectar negativamente la estética del acuario.
Si bien es cierto que los canutillos colocados en el sustrato podrían servir como escondrijos para algunos habitantes del acuario, esta función es secundaria y no sustituye la necesidad de una filtración biológica eficiente. Las plantas naturales, por ejemplo, ofrecen un mejor aspecto estético y son consumidoras directas de nitratos, complementando de manera más efectiva la filtración.
La Importancia de las Etapas de Filtración en un Filtro Convencional
Un filtro de acuario bien diseñado no se limita a un solo tipo de material. Generalmente, consta de varias etapas que trabajan en conjunto para ofrecer una filtración completa:
- Filtración Mecánica: Inicialmente, el agua pasa por esponjas o materiales prefiltros que retienen las partículas más grandes en suspensión (restos de comida, heces, hojas muertas). Esto evita que estos desechos lleguen a las etapas posteriores y obstruyan el material biológico.
- Filtración Biológica: Aquí es donde entran en juego los canutillos cerámicos y otros materiales porosos. La gran superficie de estos medios permite el desarrollo de una densa colonia bacteriana que procesa el amoníaco y los nitritos.
- Filtración Química (Opcional): Algunos filtros incorporan carbón activado u otros materiales químicos para eliminar olores, coloraciones o ciertas toxinas del agua.
- Filtración Fina: Al final del proceso, el agua puede pasar por materiales aún más finos, como perlón o esponjas de alta densidad, que retienen las partículas más pequeñas que hayan podido pasar las etapas anteriores, dejando el agua cristalina.
Este sistema secuencial garantiza que lo que no fue consumido o retenido en una etapa, sea procesado en la siguiente. Un circuito veloz donde cada etapa tiene bacterias, y lo que no consumieron las primeras, lo consumirán las posteriores, garantizando agua de menor contenido de contaminantes.

Canutillos Cerámicos en Acuarios Pequeños o Específicos
En acuarios muy pequeños, como los gambarios, donde se suelen utilizar filtros de esponja y el espacio para añadir más material filtrante es limitado, colocar canutillos cerámicos dentro de la esponja o en un compartimento adicional del filtro de esponja puede ser una buena estrategia. En estos casos, se busca complementar la filtración mecánica de la esponja con una capacidad biológica adicional.
Consideraciones Adicionales y Consejos Prácticos
- Cantidad de Canutillos: La cantidad necesaria de canutillos cerámicos varía según el volumen del acuario y la carga biológica (cantidad de peces y su tamaño). Una regla general común sugiere alrededor de 0.5 kg por cada 80-100 litros de agua, pero esto es una aproximación y puede necesitar ajuste.
- Limpieza de Canutillos: La limpieza de los canutillos es crucial para mantener su efectividad. Nunca deben lavarse con agua del grifo, ya que el cloro puede matar las bacterias beneficiosas. Lo ideal es enjuagarlos suavemente con agua del propio acuario, utilizando un recipiente aparte, para eliminar la suciedad acumulada sin dañar la colonia bacteriana.
- Ciclado de Canutillos Nuevos: Los canutillos nuevos no vienen "ciclados", es decir, no tienen bacterias beneficiosas adheridas. Para introducirlos en un acuario, se deben ciclar previamente. Esto se puede hacer colocándolos en un acuario ya establecido y en funcionamiento durante varias semanas, o utilizando productos específicos para acelerar el ciclado.
- Canutillos Ciclados para Transferencias: Si se inicia un nuevo acuario y se desea acelerar el proceso de ciclado, se pueden usar canutillos ciclados de un acuario maduro. Esto transfiere una colonia bacteriana ya establecida al nuevo sistema.

En resumen, si bien la idea de utilizar canutillos cerámicos como parte del sustrato puede surgir de la intención de ahorrar costos o de buscar soluciones alternativas, su ubicación óptima y más eficiente es dentro de un sistema de filtración. Un filtro diseñado adecuadamente, con sus canutillos cerámicos alojados en su interior, asegura la circulación de agua necesaria para el desarrollo de una colonia bacteriana robusta, garantizando así una calidad de agua superior y un entorno saludable para todos los habitantes del acuario.
¿Cómo hacer un filtro casero para tu acuario?
tags: #filtro #con #canutillos